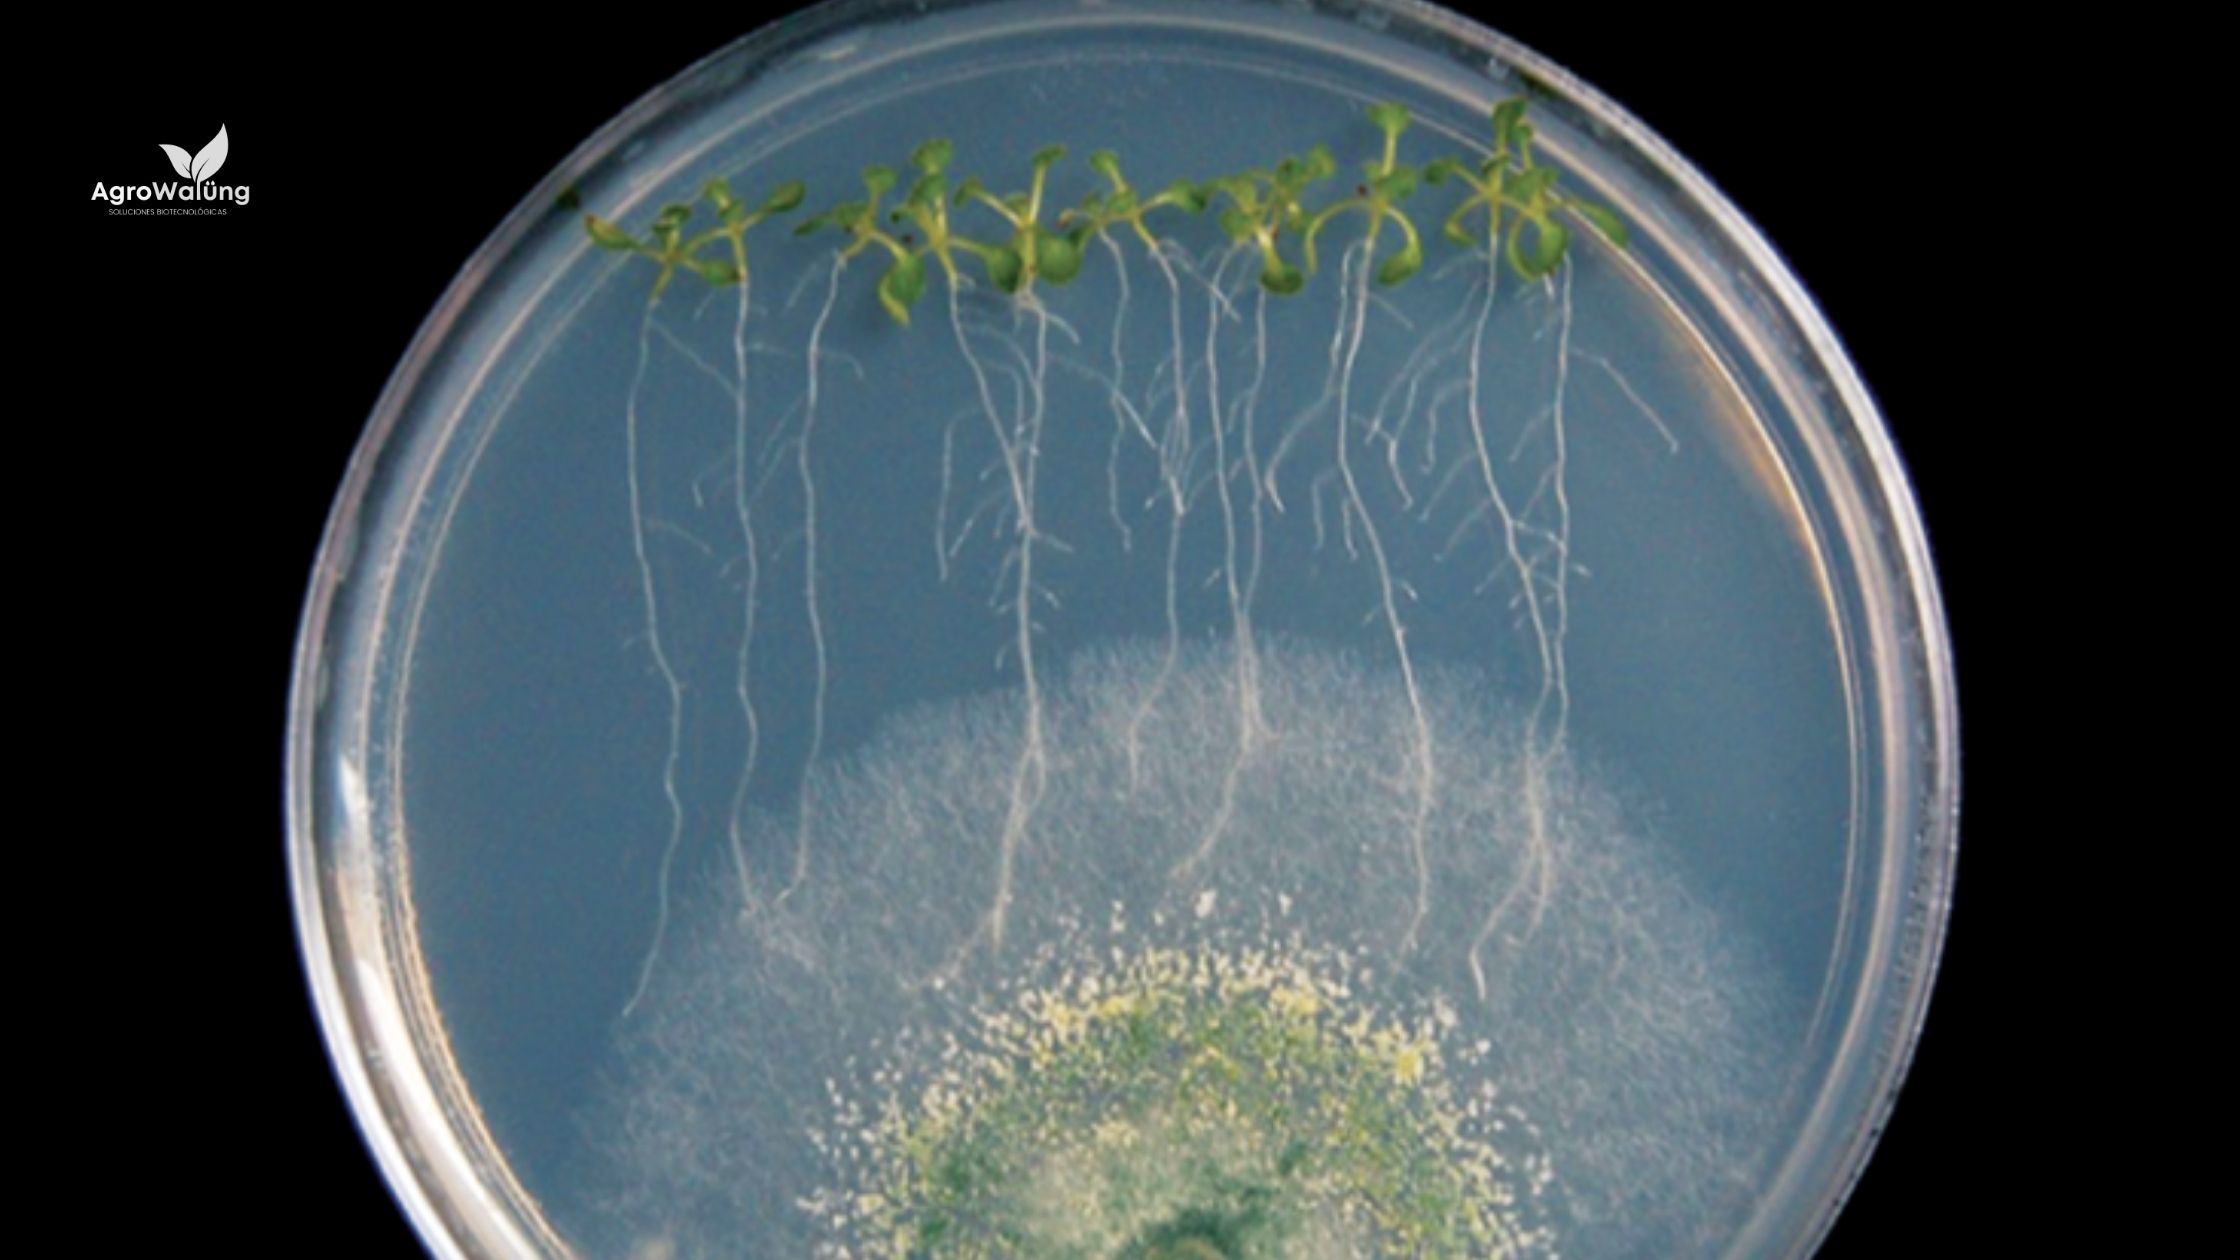

Soluciones Inteligentes
Encuentra todo lo que necesites en agricultura orgánica, manejo sustentable de cultivos y extensionismo.
Precios justos
Entregamos un producto a precio justo, y no te hacemos comprar más de lo que necesitas para tus cultivos.
Envío a tiempo
Contamos con proveedores locales en toda la costa del Maule Sur, por lo que podemos atenderte a tiempo.
Te ayudamos
El uso de productos orgánicos requiere de un adecuado manejo agronómico, sabes que no es fácil y te orientamos gratis.

Apoyo en manejo sustentable
Con el apoyo de organismos benéficos para el medio ambiente desarrollamos un plan de trabajo que apoya a la agricultura sustentable y mantiene tus cultivos sanos y libres de trazas químicas.
Vender más y mejor
El manejo orgánico de cultivos da acceso a nuevos y mejorados mercados. Actualmente existen muchas empresas que prefieren la agricultura orgánica por sobre el manejo tradicional. ¿Deseas acceder a clientes que estén dispuestos a pagar más por cultivos libres de químicos?

Conocemos tus necesidades
Somos un equipo profesional con agrónomos, especialistas en biotecnología, científicos y laboratoristas. Nuestra propuesta es llegar a un precio justo para ti.
¿Deseas conocernos?
Trabajemos en conjunto con una agricultura de alto nivel
Contáctanos para recibir nuestra asesoría inicial gratuita, donde te diremos qué productos sirven para tus necesidades y qué requieres para implementarlo. No tiene costo para ti, y si tienes suerte, te demos una muestra de prueba! : )